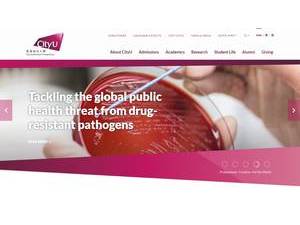
City University of Hong Kong's official website homepage screenshot

University Overview
Founded in 1984, City University of Hong Kong is a non-profit public higher education institution located in the urban setting of the large metropolis of Hong Kong (population range of over 5,000,000 inhabitants), Kowloon City. Officially recognized by the Education Bureau of Hong Kong, City University of Hong Kong (CityU) is a medium-sized (uniRank enrollment range: 9,000-9,999 students) coeducational HK higher education institution. City University of Hong Kong (CityU) offers courses and programs leading to officially recognized higher education degrees such as pre-bachelor's degrees (i.e. certificates, diplomas, associate or foundation), bachelor's degrees, master's degrees and doctorate degrees in several areas of study. See the uniRank degree levels and areas of study table below for further details. This 41-year-old HK higher-education institution has a selective admission policy based on entrance examinations and students' past academic records and grades. The acceptance rate range is 30-39% making this HK higher education organization a very selective institution. International students are welcome to apply for enrollment. CityU also provides several academic and non-academic facilities and services to students including a library, housing, sports facilities, financial aid and/or scholarships, study abroad and exchange programs, as well as administrative services.
University Snapshot
Control
![]() public
public
Entity
![]() non-profit
non-profit
Size
![]() medium-sized
medium-sized
Selectivity
![]() very selective
very selective
University Identity
| Name | City University of Hong Kong |
|---|---|
| Name (English) | n.a. |
| Name (Non Latin) | 香港城市大學 |
| Acronym | CityU |
| Founded | 1984 |
| Motto | Officium et Civitas |
| Colours | |
| Mascot | |
| Screenshot | |
| Video Presentation | n.a. |
University Location
| Address | 83, Tat Chee Avenue, Kowloon Hong Kong Kowloon City Hong Kong |
|---|---|
| Location Map and Satellite View | |
| 3442 9317 | |
| 3442 0337 | |
| Other locations |






Social Media
Official Social Media Channels
City University of Hong Kong's Facebook page review
City University of Hong Kong's X page review
City University of Hong Kong's Youtube page review
City University of Hong Kong's Instagram page review
City University of Hong Kong's official LinkedIn profile
n.a.
Related Guide Articles
Social media can be a powerful tool for Universities to communicate with current students, alumni, faculty, staff and the wider community. But how can social media be important for prospective students? Read our article about the importance of Social Media for universities and prospective students to learn more.